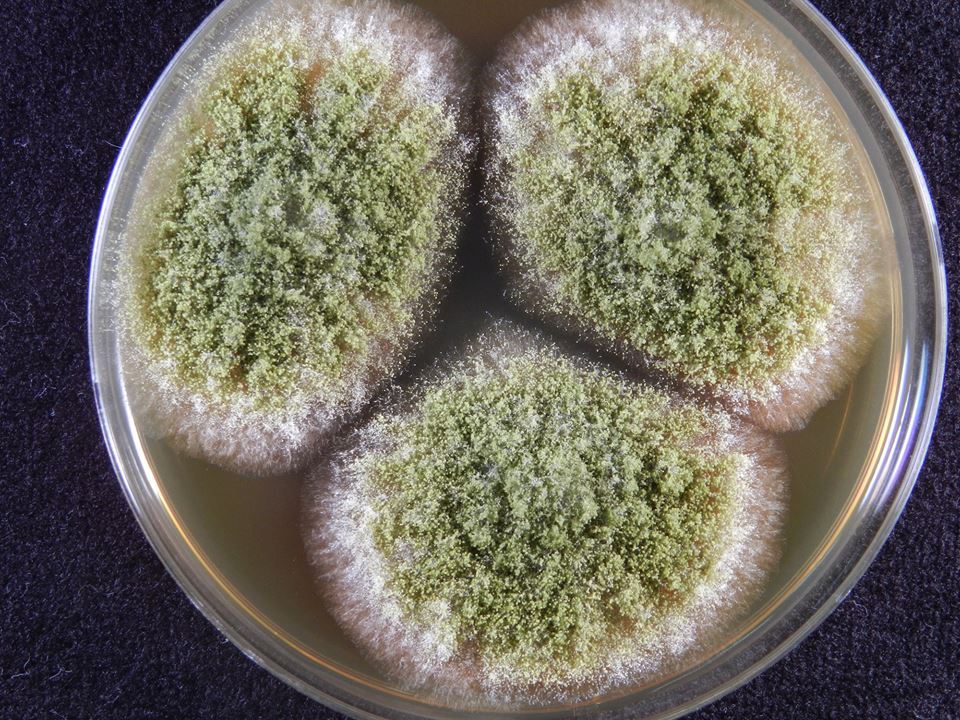
황국균 배양 사진.jpg

누룩 麴?
곰팡이 이야기 7
麴(누룩 국)에 이런 뜻이 담겨 있다니! 전율을 느끼며 공부하는 행복을 느꼈습니다.
어제까지.
麴,
이 글자(중국어 qu)는 BC 300년 주례(周禮, Zhouli)라는 책에 처음으로 등장하였습니다(History of Koji, 2012). 정확하게 표현하면 같은 글자 모양은 아니고 같은 의미를 나타내는 유사한 글자가 주례에 기록되었습니다 (어떤 글자 모양이었는지는 찾지를 못하였습니다).
이어 121년의 ‘설문해자(說文解字)’라는 책에 ‘qu' 자는 국화 국(菊)자위에 대죽(竹) 부수가 올려져 있다고 되어 있습니다. Huang(2000)*은 대나무 바구니에 담긴 찐쌀에 노란 국화 모양의 곰팡이가 피었다는 의미로 해석하였습니다.
설문해자의 글자와 우리나라에서 사용하는 국자가 모양이 같지는 않을 걸로 판단됩니다만 麴자를 다시 보게 됩니다. 오른 쪽 변의 匊이 국화(菊花) 모양의 노란 곰팡이를 의미한다면 좌변의 글자는 麥입니다. 보리입니다. 누룩은 보리가 아니라 주로 밀로 만드는데 그럼 밀은 한문으로 어떻게 쓰는지를 알아보고 전율을 느꼈습니다.
밀을 한문으로 小麥이라고 쓰는 것이 아니겠습니까! 麥자를 다시 찾아보니 보리를 포함하여 귀리, 메밀, 밀 등 곡물을 대표하는 글자랍니다. 그러면 좌변의 麥은 밀을 포함하는 곡물을 뜻하고 우변 匊은 노란국화 모양으로 핀 곰팡이를 뜻합니다. 麴자가 명쾌하게 해석이 되지 않겠습니까? 즉 麴자는 밀로 만든 누룩에 노란 국화같은 노란 곰팡이(黃麴菌)가 발생한 것을 표현하고 있습니다. 이는 현재 우리 누룩과 유사한 형상인데 놀랍지 않나요?
--------------------------------
위는 지난주 일요일의 글입니다.
어제는 이 글에 대하여 이미지를 추가하고자 하였습니다. 麴의 匊이 노란국화를 의미한다는 이미지를 찾아 같이 게시하고자 하였습니다. 그런데 몇 시간을 찾아 헤매도 누룩의 황국균(黃麴菌)이 황국(黃菊) 모양을 나타낸 사진 찾을 수가 없었습니다. 노란 국화를 연상시킬 수 있는 이미지를 보여드리고자 현미경 사진도 함께 제공합니다만,

< 황국균 배양 사진, 저자 사진>

<황국균 해부현미경 사진, 저자 사진>

<황국균 현미경 사진, 저자 사진>
설령 이 이미지가 노란 국화와 조금 비슷하다 하드라도 BC 300년에 이 글자를 만든 사람이 현미경으로 보고 글자를 만들지는 않았을 것 아닙니까? 즉 匊이 황국균을 나타내기는 어려울 걸로 저는 생각했습니다.
이번에는 국화(菊花)의 이미지를 다시 자세히 보았습니다. 자세히 볼수록 황국균과 서로 닮았다고 하기는 어려웠습니다. 그런데 의도치 않게 국화의 또 다른 면을 보게 되었습니다. 국화가 일본 황실의 문장으로 사용되고 벚꽃과 함께 일본의 대표 꽃이라고 하네요.
무언가에 낚인 이 느낌!
P.S.)
1) 인문과학이 짧아서요. 이 분야 전문가들의 도움 요청합니다.
Aspergillus 라는 곰팡이의 우리나라 이름에 대하여 고민하고 있습니다. 지난번에 이야기한대로(곰팡이 이야기 6) 중국은 曲霉(곡매), 일본은 麴黴(こうじかび, 코오지카비)라고 부릅니다. 즉 양국은 Aspergillus의 이름으로 麴의 의미를 쓰고 있습니다. 이를 감안한다면 우리는 麴菌(국균)이라고 하는 것이 타당합니다.
다만 중국과 일본에서의 曲, 麴이라는 글자는 발효된 쌀, 보리, 밀, 콩 등의 곡물을 의미합니다. 술, 된장, 간장 등의 음식을 만들기 위한 누룩, 메주, 홍국쌀 등이 모두 麴(코지)입니다. 그런데 우리나라에서는 이를 누룩으로 뜻풀이를 하는데 그러면 의미가 술 제조에 한정되어 원래의 麴자와 의미가 달라집니다.
그럼, Aspergillus를 麴菌이라 쓰고 뭐라 읽으면 좋을까요?
2) 일본과 각을 세우고 싶은 의도는 없고 이를 싫어합니다만 麴을 黃麴으로 해석하는 것은 지나치게 나아갔다는 생각이 듭니다. 좀 더 확인이 필요합니다. 아시는 분 도와 주셔요.
참고문헌)
Shurtleff W., Aoyagi A. 2012. History of koji, grains and/or soybeans enrobed with a mold culture.
Huang, H.T. 2000. Ferments In: H.T. Huang. 2000. Science and Civilisation in China.